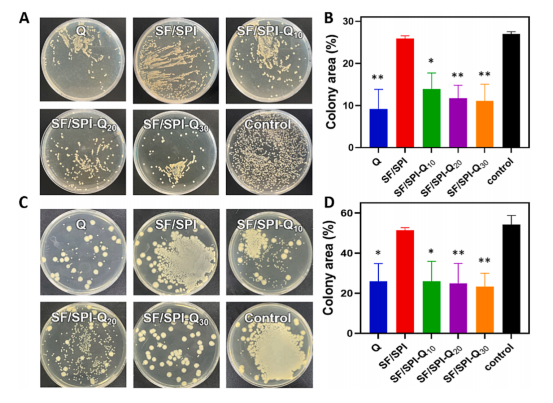
图片

商家推荐
胎牛血清 BS-1102
¥358
咨询无外泌体胎牛血清 BS-1205
¥1200
咨询胎牛血清 BS-1101
¥168
咨询金源康胎牛血清FBS-301/FBS-300/FBS-303
¥2700
咨询透析胎牛血清 BS-1202
¥750
咨询
万千商家帮你免费找货
0 人在求购买到急需产品
- 详细信息
- 申请记录(17)
- 文献和实验
- 技术资料
- 供应商:
金源康
- 库存:
充分
- 规格:
50ml/500ml
| 规格: | 50ml | 产品价格: | ¥223.0 |
|---|---|---|---|
| 规格: | 500ml | 产品价格: | ¥2150.0 |
更多试用产品:
| 金源康胎牛血清FBS-303,点击申请 |
| 金源康胎牛血清FBS-300,点此申请 |
产品介绍:
产品简介
来源于我国呼伦贝尔和锡林郭勒天然牧场健康剖腹产胎牛,按GMP生产质量管理规范全自动灌装生产,批量大(采用4000L混合罐,最大批量500mL/瓶×8000瓶)、批间差小。
适用范围
适用于培养部分干细胞、免疫细胞;常规肿瘤细胞、难培养细胞、原代细胞等。
使用方法
1) 本品经过0.1微米过滤除菌,无需再次过滤除菌。
2) 为避免沉淀增多,血清在融化过程中,须间歇的摇晃均匀。
3) 若一次无法用完1整瓶,建议在无菌环境下分装,-15℃冷冻保存,避免反复冻融。
包装规格
10mL/瓶、50mL/瓶、500mL/瓶
保存条件及有效期
-15℃以下冷冻保存,避免反复冻融,自生产之日起有效期为5年。
注意事项:如有以下情况,请勿使用
1) 包装有破损
2) 溶液浑浊,有污染的疑虑
3) 使用时已超出规定有效期
声明:仅用于研究和进一步生产,不得直接用于人或动物。
风险提示:丁香通仅作为第三方平台,为商家信息发布提供平台空间。用户咨询产品时请注意保护个人信息及财产安全,合理判断,谨慎选购商品,商家和用户对交易行为负责。对于医疗器械类产品,请先查证核实企业经营资质和医疗器械产品注册证情况。
 申请记录
申请记录 文献和实验
文献和实验据统计,中国每年约有2600万人发生不同程度的烧烫伤,占总人口的2%,死亡人数仅次于交通事故,而且烧烫伤给患者带来巨大的生理痛苦、严重的心理负担与经济损失。


因此,开发性能优良的烧烫伤敷料备受关注。大豆蛋白(SPI)是一种从天然大豆中提取的丰富而廉价的蛋白质,结构与组织细胞外基质的成分相似。

丝素蛋白(SF)具有天然的再生能力,基于SF的水凝胶能够促进对伤口愈合至关重要的各种类型细胞的生长,是优秀的伤口敷料材料。基于此,本文制备了丝素蛋白/大豆蛋白水凝胶,并负载天然抗菌药物槲皮素,得到一种兼具良好理化性质和促进伤口愈合性能的SF/SPI-Q复合水凝胶。


SF/SPI-Q水凝胶的含水量高、抗氧化性强、抗菌和抗炎效果明显,且无刺激性、无细胞毒性,能够促进细胞的增殖和迁移,还可以为伤口维持湿润的环境,并通过促进表皮再生、胶原沉积和血管生成来促进皮肤烫伤伤口的恢复,是一种极具应用潜力的烧烫伤敷料。


壁上. 最后视网膜都没了。 (五)我的窍门或者心得体会 首先我用的容器是1. 5毫升的无菌EP管. 一个可以放下1. 5毫升的无菌EP管的冰盒. 还有最重要的一个器具-- handy Pestle微量匀浆器. 日本TOYOBO公司. 货号是: h MX-301. 这种器具最大的特点就是. 它的头端是一个分叉的结构. 有四个叉. 这样一来. 当你用它来挤压放在EP管中的视网膜组织时. 由于EP管的底部是圆锥形的. 那么由于挤压的原因. 器具头端的四













